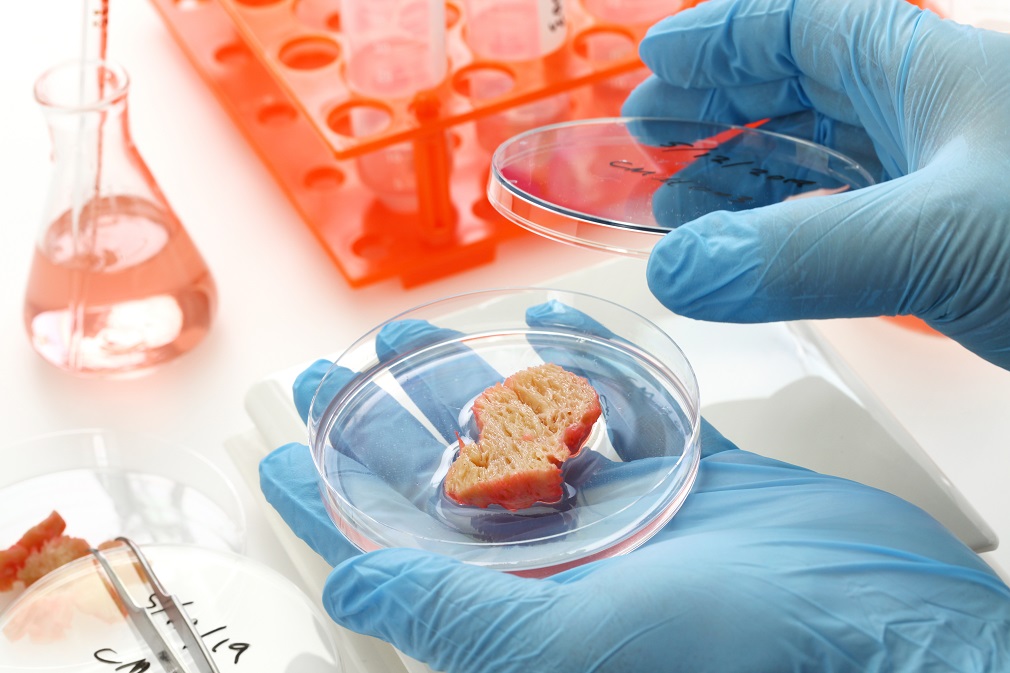

Laboratorijsko ili kultivisano meso se dobija uzgojem životinjskih ćelija. Veruje se da će ovakav način proizvodnje imati brojne koristi za planetu, prvenstveno kroz smanjenje ugljeničnog otiska. Međutim, nova studija pokazuje da je laboratorijsko meso čak 25 puta štetnije za klimu od govedine, piše Jelisaveta Perišić za „Balkan Green Energy News“.
 Proces proizvodnje laboratorijskog mesa je pozajmljen iz regenerativne medicine. Razvio ga je profesor Mark Post sa Univerziteta u Mastrihtu, koji je ranije radio na ljudskom srčanom tkivu. Post je prvi hamburger uzgojio 2013. godine.
Proces proizvodnje laboratorijskog mesa je pozajmljen iz regenerativne medicine. Razvio ga je profesor Mark Post sa Univerziteta u Mastrihtu, koji je ranije radio na ljudskom srčanom tkivu. Post je prvi hamburger uzgojio 2013. godine.
Ćelije za razvoj mesa se uzimaju biopsijom iz životinje, a zatim se stavljaju u toplu, sterilnu posudu sa rastvorom koji se naziva medijumom za rast. To sredstvo sadrži hranljive materije: soli, proteine, ugljene hidrate, vitamine i aminokiseline.
Ćelije se udvostručavaju na svaka 24 sata, a iz malog uzorka vremenom nastaju bilioni njih. Formiraju primitivna mišićna vlakna i jestivo tkivo koje se može koristiti. Postupak se može obaviti sa ćelijama različitih životinjskih vrsta. Na primer, da bi se proizvela govedina, koriste se matične ćelije krave.
Naizgled, ovo deluje kao savršeno rešenje za zaštitu životne sredine. Nije potreban masovan uzgoj stoke, koji zahteva veliku količinu hrane i vode i zauzimanje velike površine zemljišta. Smanjenjem obima uzgoja stoke smanjuju se i emisije metana i azot-oksida. Ipak, šta kada počne masovna industrijska proizvodnja?
Rezultati istraživanja koje su sproveli naučnici sa odeljenja za nauku o hrani i tehnologiji Univerziteta Kalifornije u Dejvisu pokazuju da će masovna proizvodnja laboratorijskog mesa imati 25 puta lošiji efekat na klimu od običnog uzgoja stoke. Studija je objavljena na serveru bioRxiv, ali još uvek nije recenzirana.
 – Trenutno se proizvodi od mesa na bazi životinjskih ćelija proizvode u malom obimu i uz ekonomski gubitak, međutim kompanije nameravaju da se industrijalizuju i omasove proizvodnju – piše u studiji.
– Trenutno se proizvodi od mesa na bazi životinjskih ćelija proizvode u malom obimu i uz ekonomski gubitak, međutim kompanije nameravaju da se industrijalizuju i omasove proizvodnju – piše u studiji.
Masovna proizvodnja podrazumeva velika, energetski intenzivna postrojenja. Naučnici su procenili količinu energije potrebnu za različite faze proizvodnje mesa u laboratoriji i uporedili je sa parametrima iz proizvodnje govedine.
Naučnici su otkrili da se pri proizvodnji jednog kilograma laboratorijskog mesa ispušta 246 do 1.508 kilograma ugljen-dioksida u atmosferu. To je četiri do 25 puta više CO2 od emisija iz proizvodnje govedine.
Singapur je za sada jedina zemlja na svetu koja je odobrila prodaju laboratorijskog mesa. Uprava za hranu i lekove Sjedinjenih Američkih Država proglasila je ovaj proizvod bezbednim za ljudsku ishranu, čime je početkom ove godine otvorila mogućnost njegove prodaje u SAD.
Od prvog hamburgera iz 2013. do kraja 2022. osnovano je preko 150 kompanija koje se bave uzgajanjem mesa u laboratoriji. Stručnjaci očekuju da će laboratorijsko meso u narednih 10 godina postati uobičajeno i zauzeti svoje mesto u frižiderima velikog broja ljudi širom sveta.
Izvor: Balkan Green Energy News
Foto: Envato